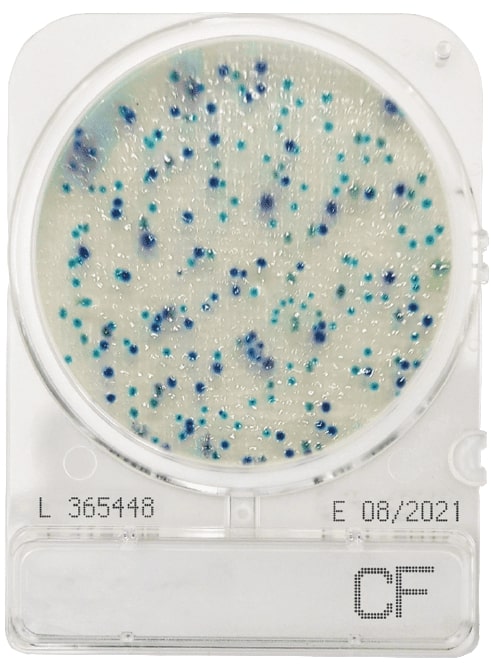

CompactDry CF (Coliformes), cx. 240 placas
338,98€ sem IVA
Marca: CompactDry
Disponível por encomenda
CompactDry CF é uma placa de meio desidratado pronta para a usar, usada para detetar bactérias coliformes em alimentos e bebidas. As bactérias coliformes são um indicador da presença de patógenos entéricos na água, carne, peixe e marisco, laticínios e outros alimentos.;
A monitorização e identificação de coliformes é utilizado em cada etapa do processo de produção de alimentos como parâmetro de controle de qualidade. O meio seletivo CompactDry CF contém o substrato enzimático cromogênico X-Gal que resulta em colônias azuis a azuis/verdes. O CompactDry CF permite ma fácil contagem de coliformes em alimentos sólidos (homogeneizados com solução tampão), amostras de água/líquidos e testes ambientais baseados em zaragatoas para superfícies e áreas de produção.